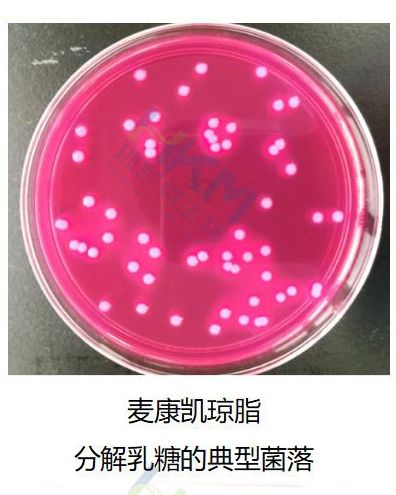
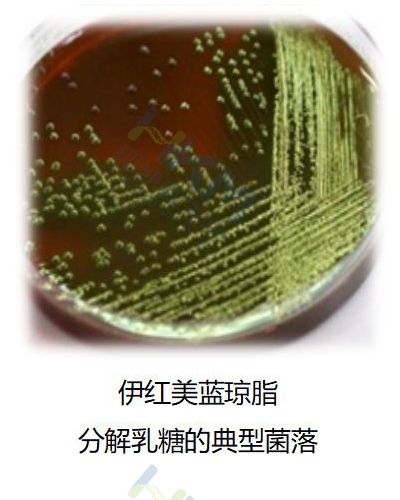

GB4789.6-2016 致泻大肠埃希氏菌检验及注意事项
发布时间:2021-11-26 浏览次数:9960 分享:
致泻大肠埃希氏菌生物学特性

致泻大肠埃希氏菌:一类能引起人体以腹泻症状为主的大肠埃希氏菌,可经过污染食物引起人类发病。
大肠埃希氏菌为革兰氏阴性短小杆菌,分类学上属于肠杆菌科大肠埃希氏菌属。
常见的致泻大肠埃希氏菌主要包括肠道致病性大肠埃希氏菌EPEC、肠道侵袭性大肠埃希氏菌EIEC、产肠毒素大肠埃希氏菌ETEC、产志贺毒素大肠埃希氏菌STEC(包括肠道出血性大肠埃希氏菌EHEC)和肠道集聚性大肠埃希氏菌EAEC。
致泻大肠埃希氏菌检验程序

操作注意事项
1:对易产生较大颗粒的样品(如肉类)进行检测时,建议使用带滤网均质袋,以便均质后用吸管吸取匀液;
2:取前增菌液接种肠道菌增菌肉汤后需在42±1 ℃温度下进行培养,该温度范围内培养有助于抑制非肠道菌生长;
3:分离划线用直径3mm的接种环(1环约10微升);
4:可疑菌落的选取,应是每个琼脂平板上分别取10~20个(10个以下的全选)乳糖发酵和不发酵的菌落;
5:在TSI培养时,应将试管口松开,保持管内有充足的氧气,否则由于氧气不足,斜面酸性产物不能氧化恢复红色。
6:大肠埃希氏菌H抗原在传代中容易丢失或发育不良,需在半固体上传代3次,观察生长,如不扩散,则表示H抗原丢失,无法做H抗原凝集试验。
培养基原理解析
营养肉汤:
胨和牛肉浸出粉提供氮源、维生素、氨基酸和碳源,氯化钠能维持均衡的渗透压,有利于损伤细菌的复苏。

肠道菌增菌肉汤:
蛋白胨提供蛋白质、维生素和氨基酸;葡萄糖提供碳源;酸氢二钠和磷酸二氢钾为缓冲剂;牛胆盐和煌绿为选择性抑菌剂,抑制非肠杆菌科细菌的生长。

麦康凯琼脂(MAC):
该培养基中含有牛胆盐和结晶紫,可抑制革兰氏阳性菌的生长,细菌发酵乳糖产酸时菌落呈粉红色并在菌落周围出现胆盐沉淀的浑浊圈。
分解乳糖的典型菌落为砖红色至桃红色,培养基周围有胆盐沉淀环;不分解乳糖的菌落为无色或淡粉色。
伊红美蓝琼脂(EMB):
乳糖作为可发酵碳源,伊红和美蓝同时作为抑菌剂和指示剂,在酸性条件下,两者结合形成黑色沉淀并可产生金属光泽。黑色程度与光泽产生情况与伊红和美蓝比例相关。
分解乳糖的典型菌落为中心紫黑色带或不带金属光泽;不分解乳糖的菌落为无色或淡粉色。
三糖铁琼脂:
该培养基含有乳糖、蔗糖和葡萄糖的比例为10:10:1,只能利用葡萄糖的细菌,葡萄糖被分解产酸使斜面先变黄,但因量少,生产的少量酸。因接触空气而氧化,加之细菌生长利用培养基中含氮物质,生成碱性产物,故斜面后来又变红。底部由于厌氧状态,酸类不被氧化,仍保持黄色。而发酵乳糖的细菌,则产生大量的酸,使整个培养基呈黄色。另外,因某些细菌能分解含硫氨基酸,生成硫化氢,硫化氢和培养基中的铁盐反应生成黑色的硫化亚铁沉淀。

氰化钾利用试验
氰化钾是细菌呼吸酶系统的抑制剂,可与呼吸酶作用使酶失去活性,抑制细菌的生长,但有的细菌在一定浓度的氰化钾存在时仍能生长,以此鉴别细菌。
结果判读:阳性为试验管和对照管都有生长变浑浊; 阴性为试验管澄清不见生长,对照管生长浑浊。

靛基质试验
某些细菌能分解蛋白胨中的色氨酸,生成吲哚。吲哚的存在可用显色反应表现出来。吲哚与对二甲基氨基苯醛结合,形成玫瑰吲哚,为红色化合物。
结果判读:阳性为滴加靛基质试剂后液面立即变玫红色; 阴性为滴加试剂后不变红色。

尿素酶试验
具有尿素酶的细菌分解培养基中的尿素,产生大量的氨,使培养呈碱性,酚红指示剂在pH6.8时呈黄色,pH8.1呈粉红色。
结果判读:阳性为玫红色; 阴性为淡橙红色-淡黄色。

生化试验结果判读 - 大肠埃希氏菌的生化特征
| 生化项目 | 结果 |
| 三糖铁 | 斜面产酸或不产酸,底层产酸,不产硫化氢 |
| 尿素(pH7.2) | 阴性 |
| 靛基质试验 | 阴性 |
| KCN | 阴性 |
取生化反应符合大肠埃希氏菌特征的菌落进行PCR确认试验
PCR确认试验 - 致泄大肠埃希氏菌特征基因

PCR试剂盒检测流程

致泻大肠埃希氏菌多重PCR试剂盒特点
致泻大肠埃希氏菌多重PCR试剂盒,各试剂盒检测的对应特征性基因如下:
| 试剂盒货号 | 检测菌株类别 | 检测基因组合 |
| KJD02P | EPEC STEC EHEC | uidA |
| bfpB | ||
| escV | ||
| stx2 | ||
| stx1 | ||
| KJD03P | EAEC | uidA |
| pic | ||
| aggR | ||
| astA | ||
| KJD04P | ETEC | uidA |
| sth | ||
| lt | ||
| stp | ||
| KJD05P | EIEC | uidA |
| invE |

| 形态 | 组分名称 | 规格×数量 |
| 冻干型 | 干粉试剂1 | 8管×3排 |
| 干粉试剂2(EIEC除外) | 8管×3排 | |
| 液态 | 复溶液 | 1mL×1管 |
| 冻干型 | 阳性对照 | 1管 |
| 阴性对照 | 1管ATCC25922 DNA | |
| 液态 | 裂解液 | 1 mL×1管 |
| 裂解液 | 1 mL×1管 | |
| loading buffer | 240 μL×1管 | |
| 说明书 | 1份 | |

血清学试验(选做项目)
取PCR试验确认为致泻大肠埃希氏菌的菌株进行血清学试验。
O抗原鉴定
1)检查培养物有无自凝性:在洁净玻片上滴一滴生理盐水,用接种环蘸少许待测培养物,混合于生理盐水内,1分钟内无凝集现象,为无自凝,反之,有自凝性。
2)假定性试验:先用大肠埃希氏菌O多价血清做玻片凝集,如果多价有凝集现象,再用多价所包含的单价O血清做试验,如与某一单价O血清有凝集反应,即为假定性试验阳性,反之为阴性。
3)确证试验:测试培养物制成3号麦氏浊度菌悬液,与假定阳性的O单价血清(原效价1:160~1:320,0.5%盐水稀释至1:40)等量混合,放50±1 ℃,培养16h,观察结果,如凝集,可证实为该O抗原。
|
|
H抗原鉴定
先穿刺半固体,有动力再做H抗原鉴定。
质量控制及疑难解析
质量控制
1: 为了控制环境污染,每次检验过程中,于检验台上打开两块计数琼脂平板,并在检验环境中暴露不少于15分钟,将此平板与本批次样品同时进行培养,以掌握检验过程中是否存在来自检验环境的污染。
2: 定期使用致泻大肠埃希氏菌标准菌株或相应定量活菌参考品,在P2实验室或阳性对照实验室内,用适当的食品样品进行阳性实验验证,染菌量应控制在10~100CFU/25g,并进行记录,次验证实验至少每2个月进行1次。
3:可以使用全自动或半自动的核酸提取仪提取DNA,但必须经过验证后使用。
4:每次PCR应使用EPEC EIEC ETEC STEC/EHEC EAEC标准菌作为阳性对照。同时使用大肠埃希氏菌ATCC25922或等效标准菌株作为阴性对照,以灭菌去离子水作为空白对照,控制PCR污染体系。
疑难解析
Q1:仅用毒力基因检测就能对致泻大肠埃希氏菌进行确认吗?
按照GB4789.6-2016要求,需要先对可疑菌落进行生化鉴定,生化鉴定为大肠埃希氏菌后,再进行毒力基因的检测,判定是何种致泻大肠埃希氏菌。因为在肠杆菌科中,一些致病也存在相同的毒力基因,所以不能对可疑菌落直接进行毒力基因检测来判定何种致泻大肠埃希氏菌。
Q2:如何看待血清型与PCR结果不符的情况?
确实有这情况存在,由于血清型判定依据是菌体抗原(O抗原、H抗原、K抗原),这些抗原并不是致泻大肠埃希氏菌发病的根本原因,而且相同血清型致泻大肠埃希氏菌中,存在不同致病型的大肠埃希氏菌,也就是说不同致泻大肠埃希氏菌“共享”同一个血清型,这是血清鉴定致泻大肠埃希氏菌的不足之处,另外,随着人类对致泻大肠埃希氏菌致病机制的认识,并找到引起不同致病型的特征性毒力基因,因此,现行标准以PCR为确认方法,而血清学诊断只是选做项目。
所需培养基试剂
| 用途 | 货号 | 名称 | 规格 |
| 样品制备 | 022010 | 营养肉汤 | 250g/瓶(干粉) |
| 22010D1 | 营养肉汤 | 225ml/袋 | |
| 增菌 | 022160 | 肠道菌增菌肉汤 | 250g/瓶(干粉) |
| 分离 | 022140 | 麦康凯琼脂培养基 | 250g/瓶(干粉) |
| 024076 | 麦康凯琼脂培养基 | 90 mm×20块/盒 | |
| 022060 | 伊红美蓝琼脂培养基 | 250g/瓶(干粉) | |
| 024087 | 伊红美蓝琼脂培养基 | 90 mm×20块/盒 | |
| 生化实验 | CP0080 | 三糖铁斜面 | 20支/盒 |
| 075240 | 蛋白胨水 | 20支/盒 | |
| 029030 | 靛基质试剂 | 10ml/支 | |
| 075150 | 尿素 | 20支/盒 | |
| 075330 | 氰化钾生长试验管 | 20支/盒 | |
| 075340 | 氰化钾对照管 | 20支/盒 | |
| HKI005 | EasyID致泻大肠埃希氏菌生化鉴定试剂盒 | 10test/盒 | |
| 071760 | 致泻大肠埃希氏菌生化鉴定盒 | 8种×10次/盒 | |
| PCR确认 | KJD02P | EPEC-STEC-EHEC多重PCR检测试剂盒 | 24测试/盒 |
| KJD03P | EAEC多重PCR检测试剂盒 | 24测试/盒 | |
| KJD04P | ETEC多重PCR检测试剂盒 | 24测试/盒 | |
| KJD05P | EIEC多重PCR检测试剂盒 | 24测试/盒 |


